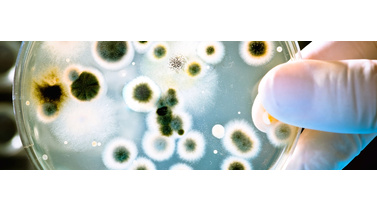
promieniowanie ultrafioletowe w lampach bakteriobójczych

Najwyżej oceniane

28
Lip
2020
Lip
2020
Prawidłowe nawodnienie organizmu - jak to zrobić?
Spożywanie odpowiedniej ilości płynów w ciągu dnia jest niezwykle ważne dla prawidłowego funkcjonowania naszej wewnętrznej gospodarki. N...
6

21
Lip
2020
Lip
2020
Słona woda po zastosowaniu zmiękczacza wody? Skąd się wzięła?
Zmiękczacz wody to niezastąpiony sposób na walkę z wysokim stopniem twardości wody. Znajduje swoje miejsce w coraz większej ilości pomie...
3

14
Lip
2020
Lip
2020
Twarda woda a domowe AGD - uważaj, jej używanie oznacza kłopoty!
Wysoki stopień twardości wody jest już całkiem dobrze znanym problemem. Mogliście wiele o nim usłyszeć, jednak czy zdawaliście sobie spr...
4

07
Lip
2020
Lip
2020
Szukasz ekologicznej i bezpiecznej butelki? Wybierz Ecoperla Ecobott
Poszukujesz dobrego sposobu na prawidłowe nawodnienie organizmu, a ulubiony napój chcesz mieć zawsze przy sobie? Zależy Ci, aby to było ...
2

30
Cze
2020
Cze
2020
Co musisz wiedzieć o kosztach eksploatacji zmiękczacza wody?
Zmiękczacze wody to coraz chętniej kupowane urządzenia do poprawy jakości wody w polskich domach. Jednak wiele osób odczuwa obawy przed ...
3

23
Cze
2020
Cze
2020
Plusy i minusy miękkiej wody - czy warto z niej korzystać w domu?
Woda stanowi nieodzowną część naszego codziennego życia. Używamy jej praktycznie przez cały dzień w różnych celach i to się tyczy każdeg...
4

16
Cze
2020
Cze
2020
Czujesz chlor w wodzie? Skąd się bierze? Czy jest niebezpieczny?
Chlor to jedna z lepiej znanych i powszechnie wykorzystywanych przez człowieka substancji. Ma dość silny zapach, co doskonale da się wyc...
3
09
Cze
2020
Cze
2020
Promieniowanie UV w lampach bakteriobójczych - czy to działa?
Prawidłowa dezynfekcja wody z własnego ujęcia jest niezwykle ważna. Tylko dzięki niej możemy zapewnić bezpieczną wodę użytkową, wolną od...
1